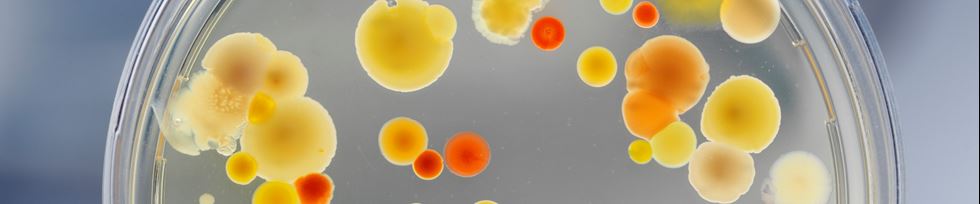

ACTION Sweden
Alliance for Clinical Trials on acute InfectiONs in Sweden

Om nätverket
ACTION Sweden är ett nationellt nätverk och en plattform för samverkan mellan Sveriges infektionskliniker och andra specialiteter i syfte att möjliggöra högkvalitativ klinisk forskning om akuta infektioner.

Pågående studier
Kartläggning av studier som sker via ACTION Sweden och studier som stöds av nätverket

Nyheter
Ta del av våra nyheter och aktuella händelser.

Gå med i ACTION Sweden
Vill du gå med i nätverket ACTION Sweden? Vill du driva en studie genom ACTION Sweden? Har du en studieidé som du vill att ACTION Sweden beforskar?
